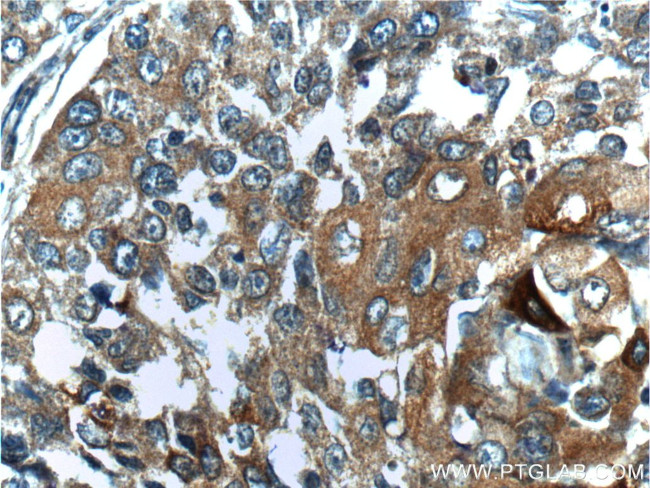
BRCA1 Antibody in Immunohistochemistry (Paraffin) (IHC (P))

Search
Proteintech
BRCA1 Polyclonal Antibody
{{$productOrderCtrl.translations['antibody.pdp.commerceCard.promotion.promotions']}}
{{$productOrderCtrl.translations['antibody.pdp.commerceCard.promotion.viewpromo']}}
{{$productOrderCtrl.translations['antibody.pdp.commerceCard.promotion.promocode']}}: {{promo.promoCode}} {{promo.promoTitle}} {{promo.promoDescription}}. {{$productOrderCtrl.translations['antibody.pdp.commerceCard.promotion.learnmore']}}
产品信息
22362-1-AP
种属反应
已发表种属
宿主/亚型
分类
类型
抗原
偶联物
形式
浓度
规格
纯化类型
保存液
内含物
保存条件
运输条件
产品详细信息
The antibody is specific to BRCA1. BRCA1 appears to produce multiple splice variants. BRCA1 is a nuclear protein with a molecular mass of 220 kDa. BRCA1D672-4095 is generated by exclusion of exon 11 by in-frame splicing and produces a 97 kDa protein. In contrast to BRCA1, BRCA1D672-4095 localizes to the cytoplasm.
Immunogen sequence: SGSLQNRNY PSQEGLIKVV DVEEQQLEES GPHDLTETSY LPRQDLEGTP YLESGISLFS DDPESDPSED RAPESARVGN IPSSTSALKV PQLKVAESAQ GPAAAHTTDT AGYNAMEESV SREKPELTAS TERVNKRMSI VVSGLTPEEF MLVYKFARKH HITLTNLITE ETTHVVMKTD AEFVCERTLK YFLGIAGGKW VVSYFWVTQS IKERKMLNEH DFEVRGDVVN GRNHQGPKRA RESQDRKIFR GLEICCYGPF TNMPTDQLEW MVQLCGASVV KELSSFTLGT GVHPIVVVQP DAWTEDNGFH AIGQMCEAPV VTREWVLDSV ALYQCQELDT YLIPQIPHSH Y (1514-1863 aa encoded by BC115037)
靶标信息
BRCA1 (breast and ovarian cancer susceptibility protein 1) is a nuclear phosphoprotein that plays a role in maintaining genomic stability and acts as a tumor suppressor in combination with other tumor suppressors, DNA damage sensors, and signal transducers to form a large multi-subunit protein complex known as BASC (for BRCA1 associated genome surveillance complex). BRCA1 associates with RNA polymerase II, and through the C terminal domain, also interacts with histone deacetylase complex. The BRCA1 protein thus plays a role in transcription, DNA repair of double-stranded breaks, and recombination. Mutations in the BRCA1 gene are responsible for approximately 40% of inherited breast cancers and more than 80% of inherited breast and ovarian cancers. Alternative splicing plays a role in modulating the subcellular localization and physiological function of this gene. Many alternatively spliced transcript variants, some of which are disease-associated mutations, have been described for this gene, but the full-length natures of only some of these variants has been described. A related pseudogene, which is also located on chromosome 17, has been identified.
仅用于科研。不用于诊断过程。未经明确授权不得转售。
生物信息学
蛋白别名: brca 1; brca-1; BRCA1/BRCA2-containing complex, subunit 1; breast and ovarian cancer susceptibility protein 1; breast cancer 1 early onset; breast cancer 1, early onset; Breast cancer type 1 susceptibility protein; breast cancer type 1 susceptibility protein isoform p.23; breast cancer type 1 susceptibility protein, isoform p.10; breast cancer type 1 susceptibility protein, isoform p.11; breast cancer type 1 susceptibility protein, isoform p.12; breast cancer type 1 susceptibility protein, isoform p.13; breast cancer type 1 susceptibility protein, isoform p.14; breast cancer type 1 susceptibility protein, isoform p.15; breast cancer type 1 susceptibility protein, isoform p.16; breast cancer type 1 susceptibility protein, isoform p.17; breast cancer type 1 susceptibility protein, isoform p.18; breast cancer type 1 susceptibility protein, isoform p.19; breast cancer type 1 susceptibility protein, isoform p.20; breast cancer type 1 susceptibility protein, isoform p.21; breast cancer type 1 susceptibility protein, isoform p.22; breast cancer type 1 susceptibility protein, isoform p.24; breast cancer type 1 susceptibility protein, isoform p.25; breast cancer type 1 susceptibility protein, isoform p.26; breast cancer type 1 susceptibility protein, isoform p.27; breast cancer type 1 susceptibility protein, isoform p.28; breast cancer type 1 susceptibility protein, isoform p.29; breast cancer type 1 susceptibility protein, isoform p.30; breast cancer type 1 susceptibility protein, isoform p.31; breast cancer type 1 susceptibility protein, isoform p.32; breast cancer type 1 susceptibility protein, isoform p.33; breast cancer type 1 susceptibility protein, isoform p.34; breast cancer type 1 susceptibility protein, isoform p.35; breast cancer type 1 susceptibility protein, isoform p.36; breast cancer type 1 susceptibility protein, isoform p.37; breast cancer type 1 susceptibility protein, isoform p.38; breast cancer type 1 susceptibility protein, isoform p.39; breast cancer type 1 susceptibility protein, isoform p.40; breast cancer type 1 susceptibility protein, isoform p.41; breast cancer type 1 susceptibility protein, isoform p.42; breast cancer type 1 susceptibility protein, isoform p.6; breast cancer type 1 susceptibility protein, isoform p.7; breast cancer type 1 susceptibility protein, isoform p.8; breast cancer type 1 susceptibility protein, isoform p.9; BROVCA12; Delta772-3095; early onset breast cancer 1; Fanconi anemia, complementation group S; influences susceptibility to breast and ovarian cancer; OTTHUMP00000212147; OTTHUMP00000212148; OTTHUMP00000212149; OTTHUMP00000212150; OTTHUMP00000212151; OTTHUMP00000212155; protein phosphatase 1, regulatory subunit 53; RING finger protein 53; RING-type E3 ubiquitin transferase BRCA1; unnamed protein product
基因别名: BRCA1; BRCAI; BRCC1; BROVCA1; FANCS; IRIS; PNCA4; PPP1R53; PSCP; RNF53
UniProt ID: (Human) P38398
Entrez Gene ID: (Human) 672